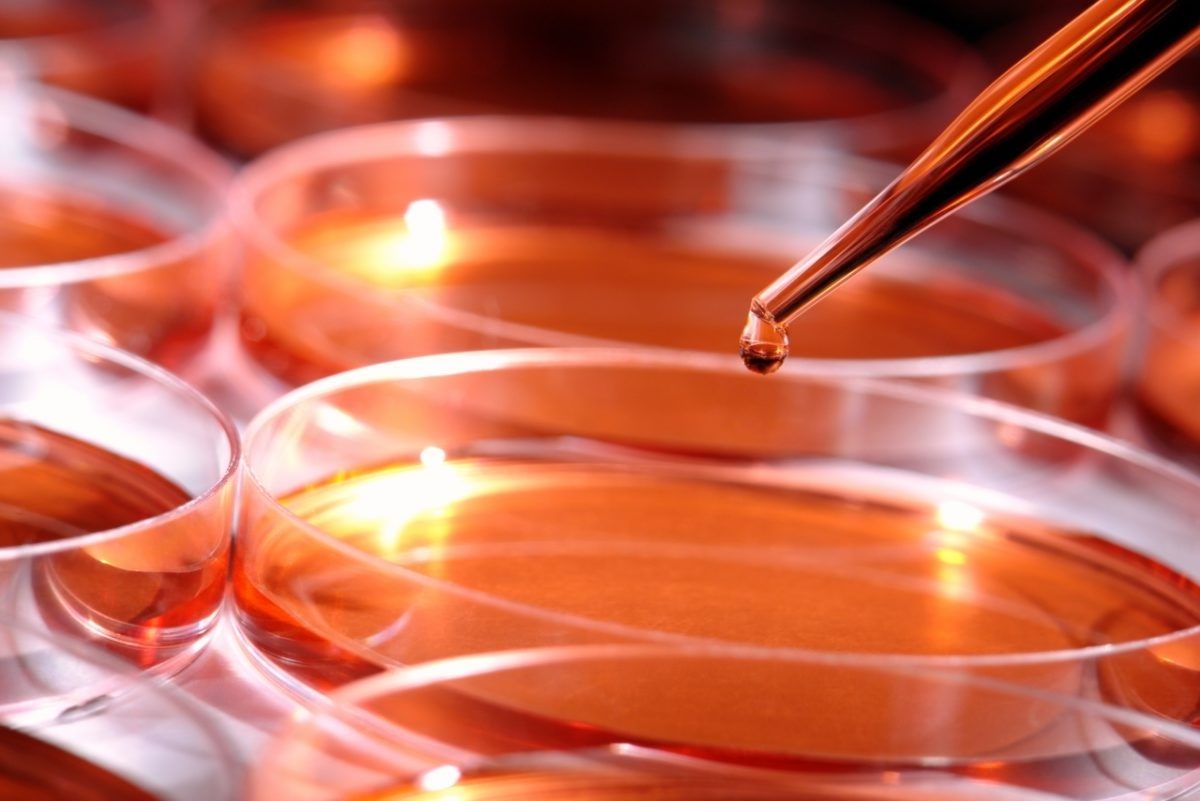

Организатор, Российская венчурная компания (РВК), площадкой под конкурс выбрала Кубанский государственный университет. В течение месяца участники с помощью экспертов, специалистов и бизнес-тренеров могли качественно улучшить свои разработки, обосновать бизнес-модели и подготовить итоговые презентации для потенциальных инвесторов. В итоге финалистами стали 12 проектов, а среди них единственный победитель — Анжела Асатурова, руководитель лаборатории создания микробиологических средств защиты растений и коллекции микроорганизмов Краснодарского ВНИИ биологической защиты растений.
«Наша команда из девяти человек, уникальных специалистов, сейчас работает над несколькими задачами, — говорит Анжела Асатурова. — Одна из них — создание новых биофунгицидов для защиты сельхозкультур от экономически значимых болезней».
Проект-победитель получил право поучаствовать в федеральном акселераторе стартапов GenerationS без предварительного отбора. Остальные финалисты тоже могут реализовать это право, но на общих основаниях.